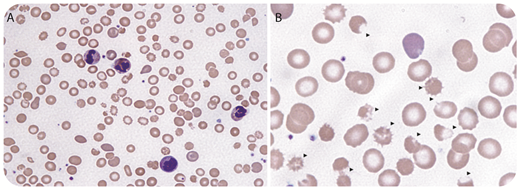
A 9-year-old boy with presumed attention-deficit hyperactivity disorder presented with jaundice/fatigue/headache/elevated creatinine/loose stools. He was investigated for acute hemolytic anemia (HA) including hemolytic uremic syndrome. His complete blood count showed: white blood cells, 16.7 × 109/L; hemoglobin, 69 g/L; reticulocytes, 214 × 109/L; platelets, 168 × 109/L (normal, 180 × 109/L to 440 × 109/L); bilirubin, 471 μM/L; lactate dehydrogenase, 896 U/L; haptoglobin, <0.07 g/L; plasma-free hemoglobin, 1.28 g/L (normal, 0.01-0.05 g/L). The blood smear (BS) demonstrated marked echinospherocytosis/target cells/polychromasia (panel A; Wright stain, original magnification ×40)/bite/blister cells (panel B; Wright stain, original magnification ×100) with no schistocytosis, consistent with oxidative hemolysis. Direct antiglobulin test/hepatitis serology/glucose-6-phosphate dehydrogenase/molecular tests for enteric pathogens including Escherichia coli O157 were negative. The patient developed fulminant hepatic failure (FHF) with: aspartate aminotransferase, 256 U/L; alkaline phosphatase, 45 U/L; γ-glutamyl transferase, 156 U/L; albumin, 21 g/L; international normalized ratio, 3.1; partial thromboplastin time, 53 seconds; and fibrinogen, 1.1 g/L. Serum ceruloplasmin was decreased 6.9 mg/dL (normal, 24-50 mg/dL); serum copper was elevated 48.4 µM/L (13.2-21.4 µM/L). A clinical diagnosis of Wilson disease with FHF was made based on the BS/laboratory tests/clinical presentations. The patient was transferred for urgent liver transplantation. / HA was the presenting manifestation in ∼5% to 6% of patients with Wilson disease, especially in children/young adults with FHF. It is believed that HA is related to the release of copper into the blood from hepatocytes necrosis, causing oxidative damage to the erythrocytes.

A 9-year-old boy with presumed attention-deficit hyperactivity disorder presented with jaundice/fatigue/headache/elevated creatinine/loose stools. He was investigated for acute hemolytic anemia (HA) including hemolytic uremic syndrome. His complete blood count showed: white blood cells, 16.7 × 109/L; hemoglobin, 69 g/L; reticulocytes, 214 × 109/L; platelets, 168 × 109/L (normal, 180 × 109/L to 440 × 109/L); bilirubin, 471 μM/L; lactate dehydrogenase, 896 U/L; haptoglobin, <0.07 g/L; plasma-free hemoglobin, 1.28 g/L (normal, 0.01-0.05 g/L). The blood smear (BS) demonstrated marked echinospherocytosis/target cells/polychromasia (panel A; Wright stain, original magnification ×40)/bite/blister cells (panel B; Wright stain, original magnification ×100) with no schistocytosis, consistent with oxidative hemolysis. Direct antiglobulin test/hepatitis serology/glucose-6-phosphate dehydrogenase/molecular tests for enteric pathogens including Escherichia coli O157 were negative. The patient developed fulminant hepatic failure (FHF) with: aspartate aminotransferase, 256 U/L; alkaline phosphatase, 45 U/L; γ-glutamyl transferase, 156 U/L; albumin, 21 g/L; international normalized ratio, 3.1; partial thromboplastin time, 53 seconds; and fibrinogen, 1.1 g/L. Serum ceruloplasmin was decreased 6.9 mg/dL (normal, 24-50 mg/dL); serum copper was elevated 48.4 µM/L (13.2-21.4 µM/L). A clinical diagnosis of Wilson disease with FHF was made based on the BS/laboratory tests/clinical presentations. The patient was transferred for urgent liver transplantation.
HA was the presenting manifestation in ∼5% to 6% of patients with Wilson disease, especially in children/young adults with FHF. It is believed that HA is related to the release of copper into the blood from hepatocytes necrosis, causing oxidative damage to the erythrocytes.
A 9-year-old boy with presumed attention-deficit hyperactivity disorder presented with jaundice/fatigue/headache/elevated creatinine/loose stools. He was investigated for acute hemolytic anemia (HA) including hemolytic uremic syndrome. His complete blood count showed: white blood cells, 16.7 × 109/L; hemoglobin, 69 g/L; reticulocytes, 214 × 109/L; platelets, 168 × 109/L (normal, 180 × 109/L to 440 × 109/L); bilirubin, 471 μM/L; lactate dehydrogenase, 896 U/L; haptoglobin, <0.07 g/L; plasma-free hemoglobin, 1.28 g/L (normal, 0.01-0.05 g/L). The blood smear (BS) demonstrated marked echinospherocytosis/target cells/polychromasia (panel A; Wright stain, original magnification ×40)/bite/blister cells (panel B; Wright stain, original magnification ×100) with no schistocytosis, consistent with oxidative hemolysis. Direct antiglobulin test/hepatitis serology/glucose-6-phosphate dehydrogenase/molecular tests for enteric pathogens including Escherichia coli O157 were negative. The patient developed fulminant hepatic failure (FHF) with: aspartate aminotransferase, 256 U/L; alkaline phosphatase, 45 U/L; γ-glutamyl transferase, 156 U/L; albumin, 21 g/L; international normalized ratio, 3.1; partial thromboplastin time, 53 seconds; and fibrinogen, 1.1 g/L. Serum ceruloplasmin was decreased 6.9 mg/dL (normal, 24-50 mg/dL); serum copper was elevated 48.4 µM/L (13.2-21.4 µM/L). A clinical diagnosis of Wilson disease with FHF was made based on the BS/laboratory tests/clinical presentations. The patient was transferred for urgent liver transplantation.
HA was the presenting manifestation in ∼5% to 6% of patients with Wilson disease, especially in children/young adults with FHF. It is believed that HA is related to the release of copper into the blood from hepatocytes necrosis, causing oxidative damage to the erythrocytes.
For additional images, visit the ASH Image Bank, a reference and teaching tool that is continually updated with new atlas and case study images. For more information, visit http://imagebank.hematology.org.